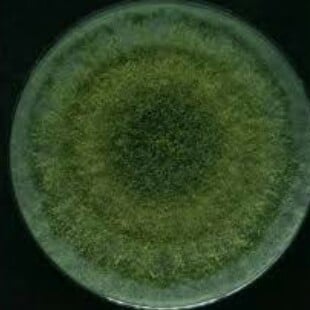

Τι είναι η μούχλα
Όλες οι μούχλες που συναντάμε στη φύση και στα σπίτια μας ανήκουν στο βασίλειο των μυκήτων, στο ίδιο δηλαδή βασίλειο με τα μανιτάρια και τις ζύμες. Είναι μύκητες που αναπτύσσουν υφές και, συνήθως, αναπαράγονται αγενώς με σπόρια που απελευθερώνουν στον αέρα. Οι περισσότερες μούχλες είναι σαπροτροφικές, δηλαδή αναπτύσσονται σαπίζοντας το υπόστρωμα που βρίσκονται και απορροφούν τα θρεπτικά που χρειάζονται. Για αυτό στη φύση δουν ως αποικοδομητές, και συμβάλουν στην ανακύκλωση των στοιχείων. Ωστόσο όμως αυτός ο τρόπος ζωής προκαλεί προβλήματα στους ανθρώπους αφού ευθύνεται για την φθορά σε έπιπλα, οικοδομικά υλικά, ή ακόμα και σε έργα τέχνης.
Πως η μούχλα εισέρχεται στα σπίτια μας
Η απάντηση στην ερώτηση αυτή είναι πως βρίσκεται ήδη μέσα στα σπίτια μας. Για την ακρίβεια τα σπόρια των μυκήτων βρίσκονται παντού στον αέρα, σε αριθμούς εως και 10.000 ανά κυβικό μέτρο. Μεταφέρονται μέσα στο σπίτι με τον αέρα και από τα ρούχα μας ή τα κατοικίδια μας, και θα αναπτυχθούν σε αποικία (κοινώς μούχλα) άμα προσγειωθούν σε πρόσφορο έδαφος. Οι περισσότερες μούχλες εμφανίζονται σε:
- Φαΐ που έχει χαλάσει (συνήθως την συναντάμε σε φρούτα, λαχανικά, ντοματοπολτούς και ψωμί)
- Περιβάλλον με πολύ υγρασία, όπως ταβάνια που στάζουν ή σε σημεία όπου υπάρχει διαρροή νερού
- Οργανικά υλικά πλούσια σε κυτταρίνη, όπως ξύλο, χαρτί και ορισμένα υφάσματα
- Υλικά ζωικής προέλευσης, δερμάτινα ή γούνινα έπιπλα και ρούχα ή χαλιά
- Διάφορες βαφές, καθώς πολλοί μύκητες ξεθωριάζουν χρώματα (και προκαλούν φθορές σε έργα τέχνης)
Κίνδυνοι στην υγεία που ευθύνονται σε μούχλα
Όταν η μούχλα είναι ορατή με το μάτι, σημαίνει ότι ο μύκητας έχει ήδη επεκτείνει τις υφές του σε όλο το υπόστρωμα και έχει ξεκινήσει να παράγει σπόρια.
Σε τροφές που μούχλιασαν, το χρωματιστό (πράσινο ή μπλε συνήθως) μέρος είναι το μέρος όπου ο μύκητας παράγει σπόρια (για την ακρίβεια το χρώμα οφείλεται στα χιλιάδες σπόρια που είναι έτοιμα να διασπαρθούν). Οι υφές του μύκητα θα έχουν ήδη εισχωρήσει σε ολόκληρο το φαΐ και θα παράγουν τοξικές και καρκινογόνες ουσίες από τον δευτερογενή μεταβολισμό τους. Για αυτό είναι καλύτερο, όταν βλέπουμε φαί που έχει μουχλιάσει, να το πετάμε ολόκληρο αντί να κόβουμε μόνο το κομμάτι που έχει μουχλιάσει.
Από την άλλη η ανησυχία όταν υπάρχει μούχλα στο σπίτι είναι ότι παράγει και απελευθερώνει τεράστια ποσά σπορίων στον αέρα. Η επαφή και εισπνοή των σπορίων προκαλεί προβλήματα όπως:
- Ρινική συμφόρηση
- Ερεθισμός των ματιών
- Φτέρνισμα
- Βήχας
- Ξηρολαιμία
- Εξανθήματά
- Πονοκέφαλος
- Ερεθισμός στο πνεύμονα
- Αλλεργικό άσθμα
Επιπλέον μπορεί να προκαλέσουν προβλήματα η να επιδεινώσουν την κατάσταση ατόμων με:
- Άσθμα
- Αλλεργίες
- Χρόνια αποφρακτική πνευμονοπάθεια
- Ανοσοκαταστολή
- Κυστική ίνωση
Επιπλέον ορισμένα είδη μυκήτων μπορούν να προκαλέσουν και μυκητιάσεις και θα αναλυθούν περεταίρω παρακάτω.
Ειδή μούχλας
Τα είδη που προκαλούν μούχλα στα σπίτια είναι πολλά, αλλά οι μούχλες που είναι πιο πιθανό να συναντήσετε ανήκουν σε ενα απο τα παρακάτω γένη.

Alternaria
Η Alternaria είναι ένας μύκητας με βελούδινη υφή και σκούρο πράσινο προς καφέ χρώμα. Σπόρια της βρίσκονται κυρίως έξω στη φύση, όπου συνηθίζει να αναπτύσσεται πάνω σε φυτική ύλη. Κατά την άνοιξη και το καλοκαίρι οι συνθήκες είναι κατάλληλες για την ανάπτυξη του μύκητα και είναι δυνατόν να εμφανιστεί σαν μούχλα σε σπίτια με υγρασία, πάνω σε σε ξύλο, σε κόντρα πλακέ, τοίχους μπάνιων και πλαστικά πολυουρεθάνης. Είναι σημαντικό όταν βρεθεί ότι υπάρχει Alternaria σε ένα σπίτι να εξυγιανθεί άμεσα, καθώς διασπείρεται ταχύτατα και τα σπόρια της προκαλούν αλλεργίες του αναπνευστικού.

Penicillium
Το Penicillium είναι ίσως η πιο κοινή αιτία μούχλας στα τρόφιμα και σίγουρα όλοι μας τον έχουμε πετύχει κάποια στιγμή στη ζωή μας. Ξεχωρίζει εύκολα από το χαρακτηριστικό μπλε-πράσινο χρώμα και την βελούδινη υφή του και παίρνει το όνομα του από την λατινική λέξη penicillatis, λόγω των κονιδιοφόρων του (δομές που ποράγουν τα σπόρια) που μοιάζουν με σκούπες. Είναι η μούχλα πού συναντάμε συχνά σε εσπεριδοειδή, στα ψωμιά, τις ντομάτες ή ντοματοπολτούς και πολλές άλλες τροφές. Επιπλέον μύκητες του γένους Penicillium αναπτύσσονται και σε σπίτια με υψηλή υγρασία, συνήθως σε χαλιά, μονώσεις τοίχων και στρώματα. Τα σπόρια του μύκητα μπορούν να προκαλέσουν σοβαρά αναπνευστικά προβλήματα, όπως φλεγμονή και άσθμα. Παρόλα αυτά, ορισμένα είδη του γένους έχουν χρησιμότητα για τον άνθρωπο, όπως το Penicillium chrysogenum από το οποίο απομονώθηκε η πενικιλίνη, ή το Penicillium roqueforti το οποίο είναι ο μπλε μύκητας του Blue Cheese.

Aspergillus
Οι μύκητες του γένους Aspergillus είναι εξίσου συχνοί στη φύση και στον αέρα, αλλά εξαιτίας της παραγωγής καρκινογόνων ουσιών, όπως η αφλατοξίνη, θεωρούνται πιο επικίνδυνοι από το γένος Penicillium. Ο μύκητας αυτός μορφολογικά εμφανίζεται σε πολλά χρώματα και μορφές, αλλά το κοινό γνώρισμα όλων των ειδών είναι οι κανονιοφόροι που έχουν το σχήμα ασπεργιλίου (όργανο με το οποίο οι παπάδες ραντίζουν αγιασμό). Συνήθως μούχλες του γένους Aspergillus είναι σκούρες πράσινες και σχηματίζουν πυκνές αποικίες σε αλυσίδες. Πέραν από την αλλεργιογόνο και καρκινογόνο δράση του μύκητα, το συγκεκριμένο γένος προσβάλλει συχνά ανθρώπους σε ανοσοκαταστολή ή με αδύναμο ανοσοποιητικό προκαλώντας ασπεργιλλίωση. Το είδος που πιο συχνά ευθύνεται για την ασπεργιλλίωση είναι ο Aspergillus fumigatus, χωρίς να είναι το μόνο.

Auerobasidium
Μύκητες του γένους Auerobasidium μπορούν να αναπτυχθούν στα σπίτια μας πίσω από ταπετσαρίες ή βαμμένες ή ξύλινες επιφάνειες. Ο μύκητας αυτός κάνει χαρακτηριστικές ροζ προς καφετί αποικίες που μελανίζουν σε μετέπειτα στάδια. Ακόμα πιο χαρακτηριστική και ενδιαφέρουσα για τους μυκητολόγους είναι η μορφή του στο μικροσκόπιο, καθώς κάνει δομές χαρακτηριστικές για τις λεγόμενες μαύρες ζύμες (μορφές ενδιάμεσες σε ζύμη και υφές). Δυστυχώς για τον απλό κόσμο, προκαλεί συχνά αλλεργίες και μολύνσεις σε οφθαλμούς, δέρμα και νύχια, οπότε δεν είναι τόσο δημοφιλής.

Mucor και Rhizopus
Οι δύο αυτοί μύκητες άνηκαν στην πρώην ταξινομική βαθμίδα των ζυγομυκήτων και είναι παρόμοιοι στην εμφάνιση. Και οι δύο κάνουν πλούσια εναέρια μυκήλια γκρι χρώματος που είναι πολύ χαρακτηριστικά στους ζυγομύκητες. Το γένος Rhizopus το συναντάμε πιο συχνά στο ψωμί, να κάνει γκρι αποικίες χνουδωτές σαν βαμβάκι. Αν το παρατηρήσετε προσεκτικά μπορεί να φαίνονται και τα σποριάγγεια του να προεξέχουν σαν σφαιρικές προεξοχές σε έναν στύλο (σποριαγγειοφόρο). Το Mucor συνήθως έχει ένα πιο ανοιχτόχρωμα γκρι και αναπτύσσεται κοντά σε κλιματιστικά ή σημεία όπου συμβαίνει συμπύκνωση υδρατμών. Είναι πολύ σημαντικό να αποφεύγετε την εισπνοή σπορίων από αυτόν τον μύκητα, χωρίς ειδικό εξοπλισμό, διότι μπορεί να μολύνει τον άνθρωπο και να προκαλέσει την λεγόμενη μουκορομυκητίαση. Σε προχωρημένα στάδια της νόσου ο μύκητας μπορεί να προκαλέσει από αλλοιώσεις στο δέρμα έως και σοβαρή νέκρωση, σε περιοχές του προσώπου και στο εσωτερικό του στόματος. Ωστόσο άτομα με υγιές ανοσοποιητικό που δεν βρίσκονται σε ανοσοκαταστολή έχουν μειωμένο κίνδυνο να μολυνθούν από αυτόν τον μύκητα.

Stachybotrys
Το γένος αυτό προκαλεί τη διαβόητη μαύρη μούχλα που αναπτύσσεται σε κλειστούς χώρους που διατηρούν σταθερά υψηλά επίπεδα υγρασίας για διαστήματα εβδομάδων. Ξεχωρίζει από την σκούρα πράσινη προς μαύρη γλοιώδη μορφή της και θεωρείται πολύ τοξικός μύκητας εξαιτίας των μυκοτοξίνων που παράγει. Συμπτώματα έκθεσης στις μυκοτοξίνες του Stachybotris είναι:
- Δυσκολία στην αναπνοή
- Βήχας
- Ιγμοριτιδα
- Εξασθένηση
- Κατάθλιψη
- Αιμορραγία απο την μύτη
- Αίσθημα καψίματος στους αεραγωγούς
- Σφίξιμο στο στήθος
Ο μύκητας αυτός είναι ιδιαίτερα επικίνδυνος για την υγεία των παιδιών, όποτε οι γονείς θα πρέπει να είναι πολύ προσεκτικοί σε περίπτωση που βρούν μαύρη μούχλα σε κάποιο σημείο του σπιτιού.
Trichoderma
Η Trichoderma είναι ένας λευκός ή πράσινος μύκητας με μαλλιαρή υφή, που συχνά εμφανίζεται ως μερικές ξεχωριστές αποικίες κοντά η μία στην άλλη, οι οποίες με τον καιρό πυκνώνουν και σχηματίζουν μία ενιαία μάζα. Όπως και οι υπόλοιποι μύκητες απαιτεί υγρασία για να αναπτυχθεί και την βρίσκουμε συχνά σε χαλιά, υγρά υφάσματα, κοντά σε κλιματιστικά και σε διάφορα οικοδομικά υλικά. Ορισμένα στελέχη του μύκητα αυτού δεν είναι τοξικά, ενώ αλλά είναι τοξικά και προκαλούν προβλήματα παρόμοια με αυτά του Stachybotrys. Το ιδιαίτερο πρόβλημα με αυτόν τον μύκητα, είναι οτι παράγει ένζυμα που φθείρουν και καταστρέφουν τα οικοδομικά υλικά σπιτιών και αμα παραμεληθεί μπορεί σε βάθος χρόνου να οδηγήσει ακόμα και σε κατάρρευση του χτιρίου. Για την σωστή απομάκρυνση του από το σπίτι απαιτείται η βοήθεια ειδικού.

Fusarium
Το Fusarium είναι ένα πολύ κοινό παθογόνο στα φυτά και για αυτό ίσως να το συναντήσει κανείς σε σαπισμένες πατάτες, καλαμπόκια, κομπόστες ή άλλα φυτικά προϊόντα. Εκτός από αυτά μπορεί να αναπτυχθεί και σε χαλιά, ταπετσαρίες, υφάσματα ή άλλα υλικά. Ο μύκητας αυτός προκαλεί μαύρισμα όταν σαπίζει φυτά όπως τις πατάτες, αλλά σε καλλιέργειες παίρνει ένα έντονο ροζ-κόκκινο χρώμα. Το Fusarium είναι παθογόνο και στον άνθρωπο, όπου μπορεί να προκαλέσει από δερματιάσεις έως και προσβολές των οστών και του εγκεφάλου. Οι τοξίνες που παράγει είναι βλαβερές για το νευρικό σύστημα και για αυτό απαιτείται εξαιρετική προσοχή όταν εντοπισθούν τροφές μολυσμένες από Fusarium.
Πως γίνεται η εξυγίανση ενός χώρου με μούχλα
Σε περίπτωση που βρείτε μούχλα μέσα στο σπίτι θα πρέπει άμεσα να απορρίψετε το αντικείμενο ή την τροφή όπου αναπτύσσεται, με όσο το δυνατόν πιο λεπτούς χειρισμούς ώστε να αποφευχθεί η διασπορά των σπορίων του μύκητα. Είναι καλή ιδέα να φοράτε μάσκα, προστατευτικά γυαλιά και γάντια όσο χειρίζεστε αντικείμενα με μούχλα και να τα κλείνετε σε μια σακούλα προτού τα πετάξετε. Επίσης είναι πολύ πιθανό οτι η μούχλα θα αναπτυχθεί σε περισσότερα από ένα σημεία μέσα στο σπίτι, οπότε καλό θα ήταν να ψάξετε και τους υπόλοιπους χώρους, κάτω από χαλιά και πίσω από ταπετσαρίες για να είστε σίγουροι.
Σε περίπτωση που η προσβολή από μύκητα έχει επεκταθεί σε μεγάλο μέρος του σπιτιού πιθανόν να χρειαστεί η βοήθεια ειδικού προσωπικού για να γίνει εξυγίανση του χώρου. Τυπικά βήματα που περιλαμβάνει η εξυγίανση είναι:
- Στέγνωμα και καλή αφύγρανση του χώρου
- Σφράγισμα των πιθανών διαδρομών εξόδου των σπορίων του μύκητα, ώστε να αποφευχθεί η διασπορά του, και εγκαθίδρυση αρνητικής πίεσης στο δωμάτιο.
- Χρήση μυκητοκτόνων στο χώρο προσβολής και απομάκρυνση όλων των σπορίων του μύκητα
- Επιδιόρθωση βλαβών αφότου ο μύκητας έχει εξαλειφθεί
Πηγή: TrueMed














